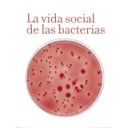

La vida social de las bacterias, con Manuel Espinosa 5x04
La vida en soledad no está hecha para ellas. Las bacterias no suben a las redes fotos de su último viaje a la raíz de una planta ni chatean con sus colegas, pero son capaces de organizarse, mandarse señales y formar comunidades muy extensas y persistentes. Llevan millones de años en el planeta, y eso les da ciertas ventajas evolutivas que desconocíamos hasta hace poco. Manuel Espinosa, investigador del CSIC y autor del libro La vida social de las bacterias nos explica los mecanismos de estos seres unicelulares para comunicarse entre sí y con otros seres vivos, nos cuenta los secretos de su capacidad para sobrevivir en los ambientes más extremos y por qué algunas ofrecen tanta resistencia a los antibióticos.
La vida social de las bacterias, con Manuel Espinosa 5x04
La vida en soledad no está hecha para ellas. Las bacterias no suben a las redes fotos de su último viaje a la raíz de una planta ni chatean con sus colegas, pero son capaces de organizarse, mandarse señales y formar comunidades muy extensas y persistentes. Llevan millones de años en el planeta, y eso les da ciertas ventajas evolutivas que desconocíamos hasta hace poco. Manuel Espinosa, investigador del CSIC y autor del libro La vida social de las bacterias nos explica los mecanismos de estos seres unicelulares para comunicarse entre sí y con otros seres vivos, nos cuenta los secretos de su capacidad para sobrevivir en los ambientes más extremos y por qué algunas ofrecen tanta resistencia a los antibióticos.